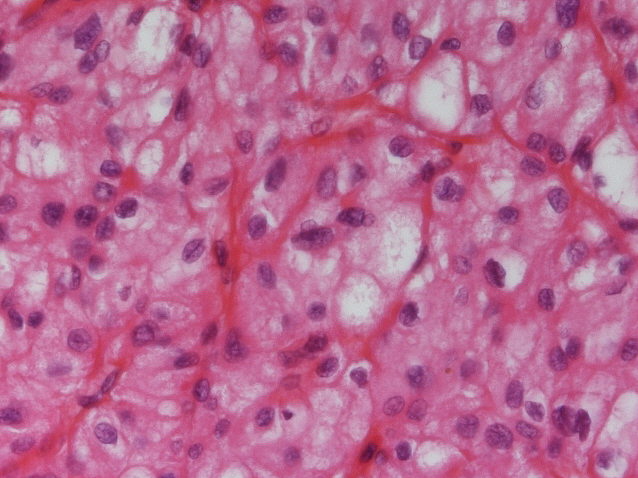

Case ID: 882
Publication date: 21 Jan, 2016
Consensus grade: Chromophobe RCC
Show diagnosis by expert panel members| User | Diagnosis | Difficulty | Comment |
|---|---|---|---|
| Pathologist 1 | Chromophobe RCC | Typical | |
| Pathologist 2 | Chromophobe RCC | Typical | |
| Pathologist 3 | Chromophobe RCC | Typical | |
| Pathologist 4 | Chromophobe RCC | Not typical |
SDH-deficient renal cell cancer if colloidal iron was negative |
| Pathologist 5 | Chromophobe RCC | Not typical | |
| Pathologist 6 | Renal cell carcinoma, unclassified | Not typical |
H&E not typical of eosinophilic chromophobe. Have seen Hale's positive cases like this that do not have chromosomal abnormilities typical of chromophobe. |
| Pathologist 7 | Chromophobe RCC | Typical | |
| Pathologist 8 | Chromophobe RCC | Typical | |
| Pathologist 9 | Chromophobe RCC | Typical | |
| Pathologist 10 | Chromophobe RCC | Typical | |
| Pathologist 11 | Chromophobe RCC | Not typical | |
| Pathologist 12 | Chromophobe RCC | Typical | |
| Pathologist 13 | Chromophobe RCC | Typical | |
| Pathologist 14 | Chromophobe RCC | Typical | |
| Pathologist 15 | Chromophobe RCC | Typical | |
| Pathologist 16 | Chromophobe RCC | Typical | |
| Pathologist 17 | Chromophobe RCC | Not typical | |
| Pathologist 18 | Chromophobe RCC | Typical |
Case description (by case creator):
another chromophob, I guess very classic, could maybe become a consensus case